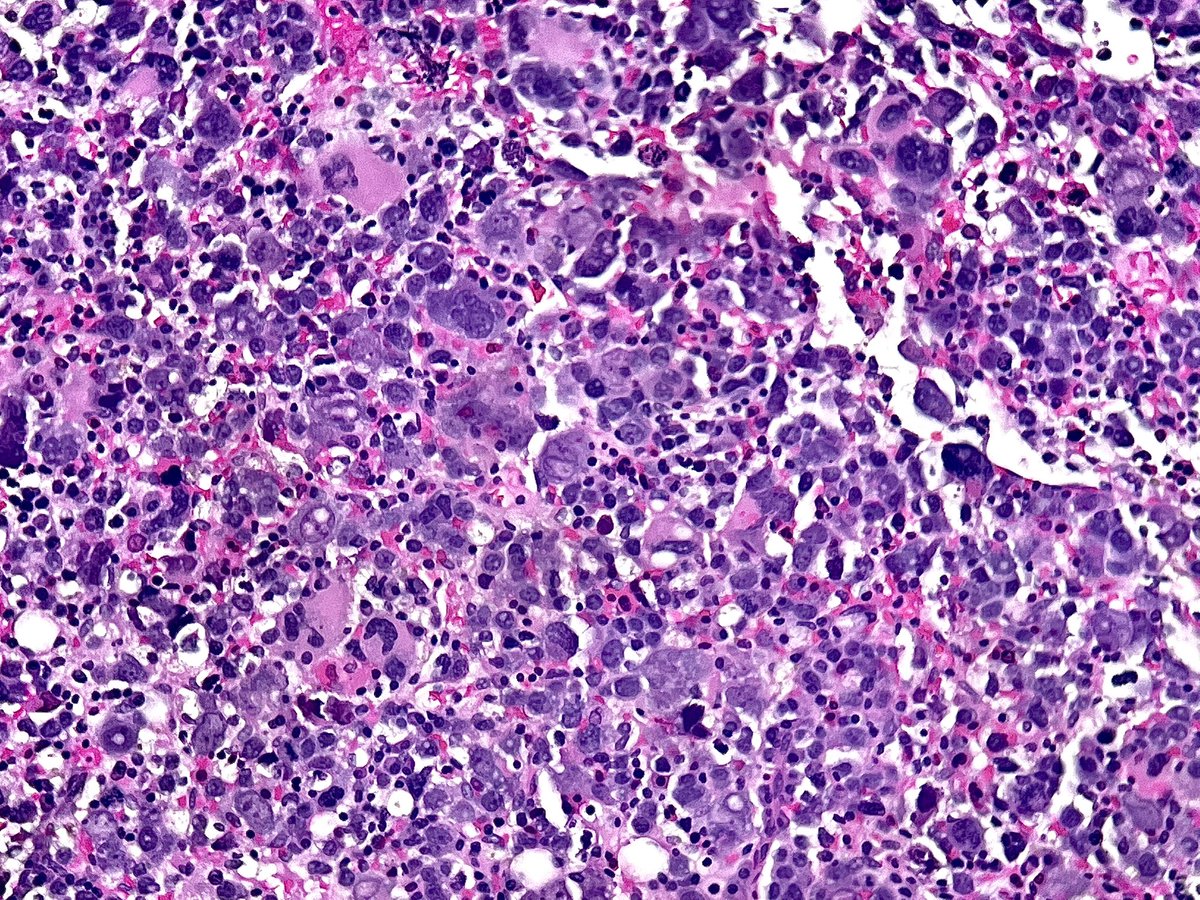
Nana Matsumoto, DO tweet media
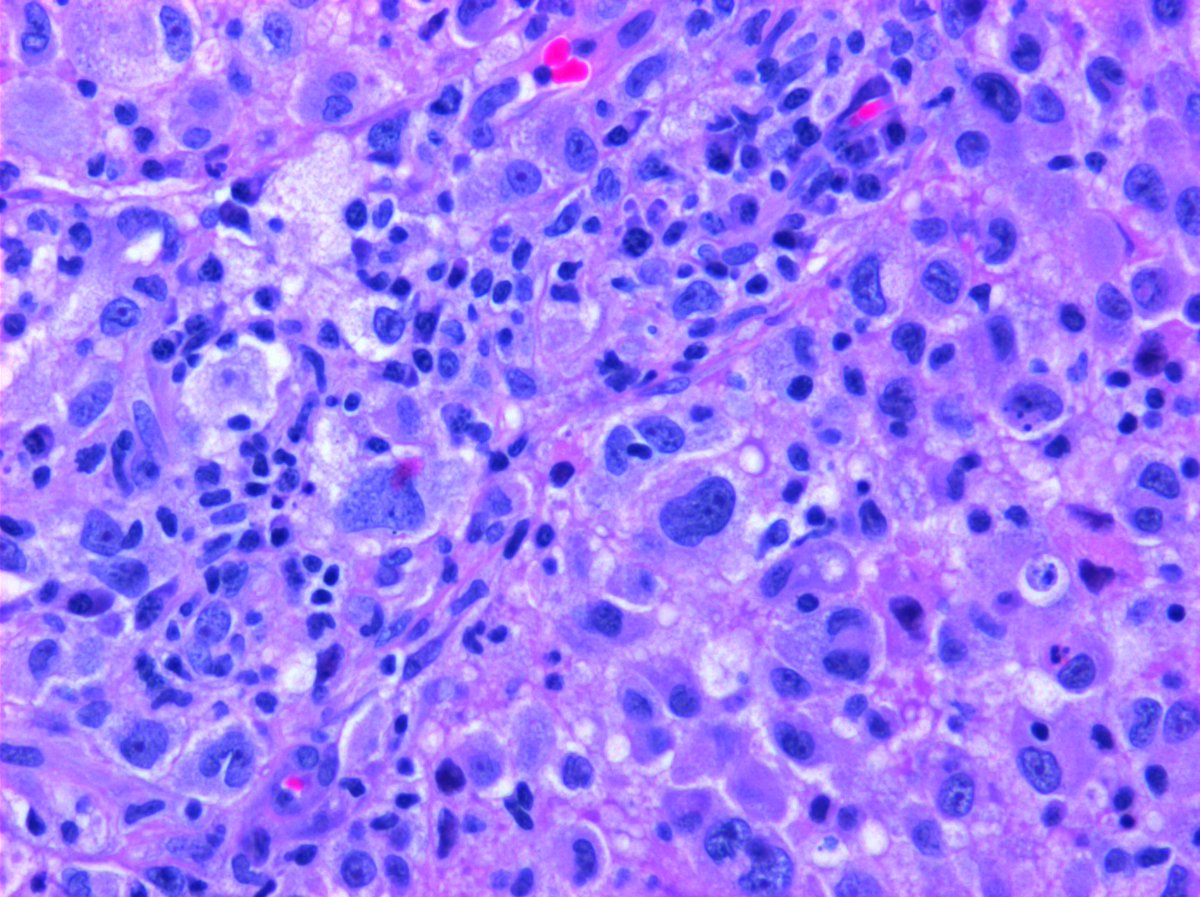
@Hemepathguy tweet media

Jamie Shah DO (She/Her) retweetledi

#GUPath #Surgpath #Pathtwitter #PathX
#Pathresidents: Let’s take a look at two biopsy cores (from the same patient) and decide what to call them.
Take a look at both cases (“A” in this post, “B” in reply). Cast your vote. Then, read on for some teaching points geared towards trainees and general fans of #GUPath.



English